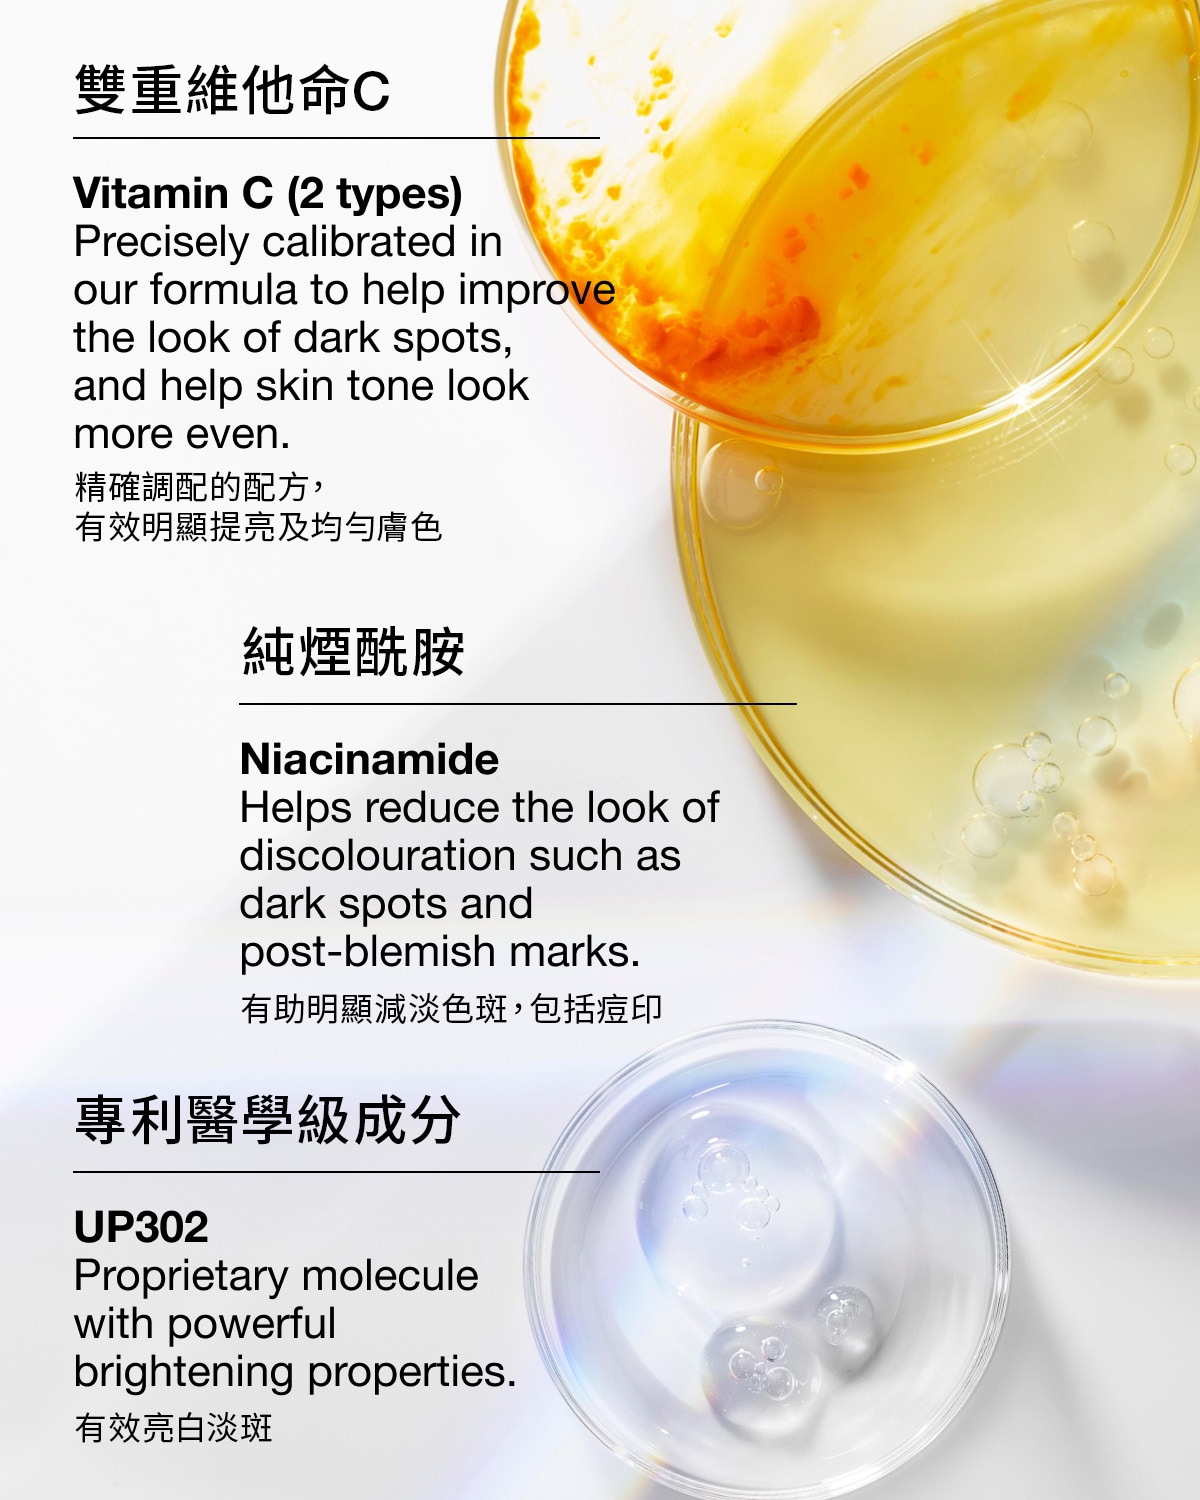

CLINIQUE Even Better Clinical™ Dark Spot Clearing Serum 50ml كلينك سيروم مضاد التصبغات للبشرة
د.ع210,250.00
سيروم التفتيح من الجيل الرابع هو حل فعال، مُطوّر من قِبل أطباء الجلدية، لبشرة مشرقة.
يُساعد على تقليل البقع الداكنة وهشاشة البشرة بشكل واضح، ويُحسّن إشراقة البشرة.
Description
سيروم التفتيح من الجيل الرابع لدينا هو حل فعال، مُطوّر من قِبل أطباء الجلدية، لبشرة مشرقة. تركيبة متطورة، تتضمن جزيئنا الحصري UP302، تُوازن بين مُكوّنات التفتيح الفعّالة ومُكوّنات مُهدئة.*مُثبّت سريريًا قدرته على مُكافحة ستة مُعوّقات تُعيق الحصول على بشرة أكثر إشراقًا: البقع الداكنة، فرط التصبغ الناتج عن ارتفاع درجة الحرارة، تفاوت لون البشرة، الشحوب، البهتان، والمسام. لطيف على جميع أنواع البشرة، بما في ذلك البشرة الحساسة.
مُطوّر ومُختبر من قِبل أطباء الجلدية. آمن للبشرة الحساسة. مُناسب للبشرة بعد العمليات الجراحية.**مُختبر سريريًا على البشرة الآسيوية. مُختبر ضد الحساسية. خالٍ من العطور بنسبة 100%.
*مقارنةً بمُصحّح البقع الداكنة الجذري Even Better Clinical™ + مُزيل البقع الداكنة.
**أثبتت الاختبارات السريرية التي استمرت أسبوعين أنه آمن للاستخدام بدءًا من يوم واحد بعد العلاج بالضوء النبضي المُكثّف (IPL).
فوائده
يعالج ستة عوائق لبشرة أكثر إشراقًا
يخفف بشكل واضح من البقع الداكنة العنيدة، وفرط التصبغ الناتج عن العوامل البيئية، وتفاوت لون البشرة، والشحوب، والبهتان، وظهور المسام.
يهدئ البشرة بشكل واضح
يساعد على تهدئة البشرة عن طريق تقليل التهيج الناتج عن العوامل البيئية المهيجة التي قد تؤدي إلى فرط تصبغ مستقبلي.
يقدم نتائج ملحوظة
تبدو البشرة أكثر إشراقًا وإشراقًا، مع لون أكثر تناسقًا. تصبح المسام أقل وضوحًا وتبدو البشرة أكثر نعومة، مما يسمح للبشرة بعكس الضوء بشكل أفضل لمظهر أكثر إشراقًا.
ملمس مريح
تركيبة خفيفة وخالية من الزيوت تمتصها البشرة بسرعة.

Reviews
There are no reviews yet.